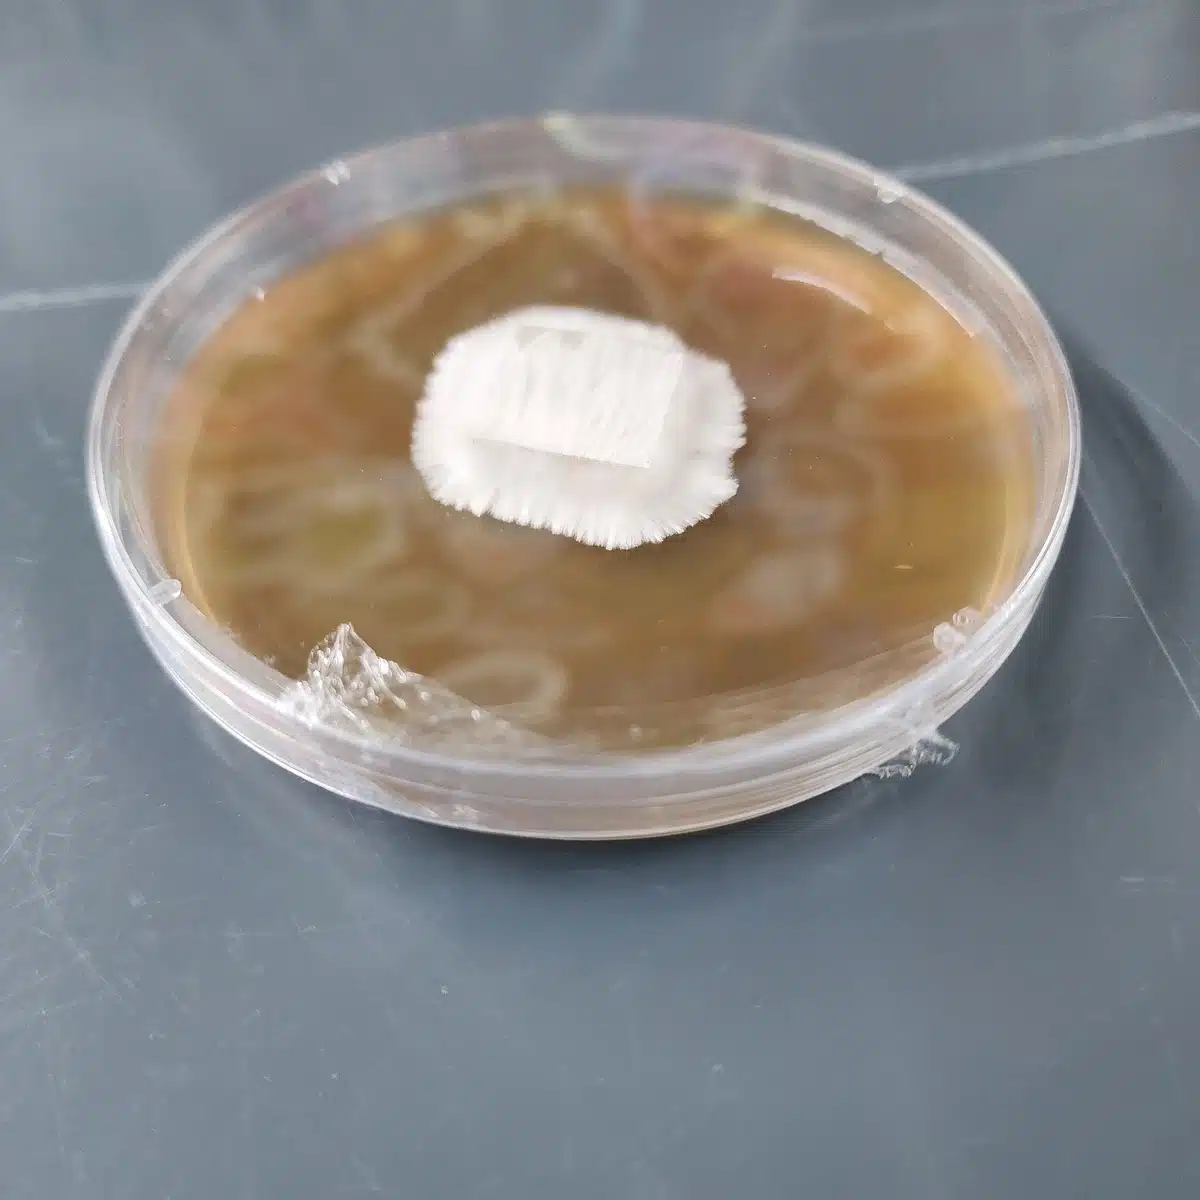
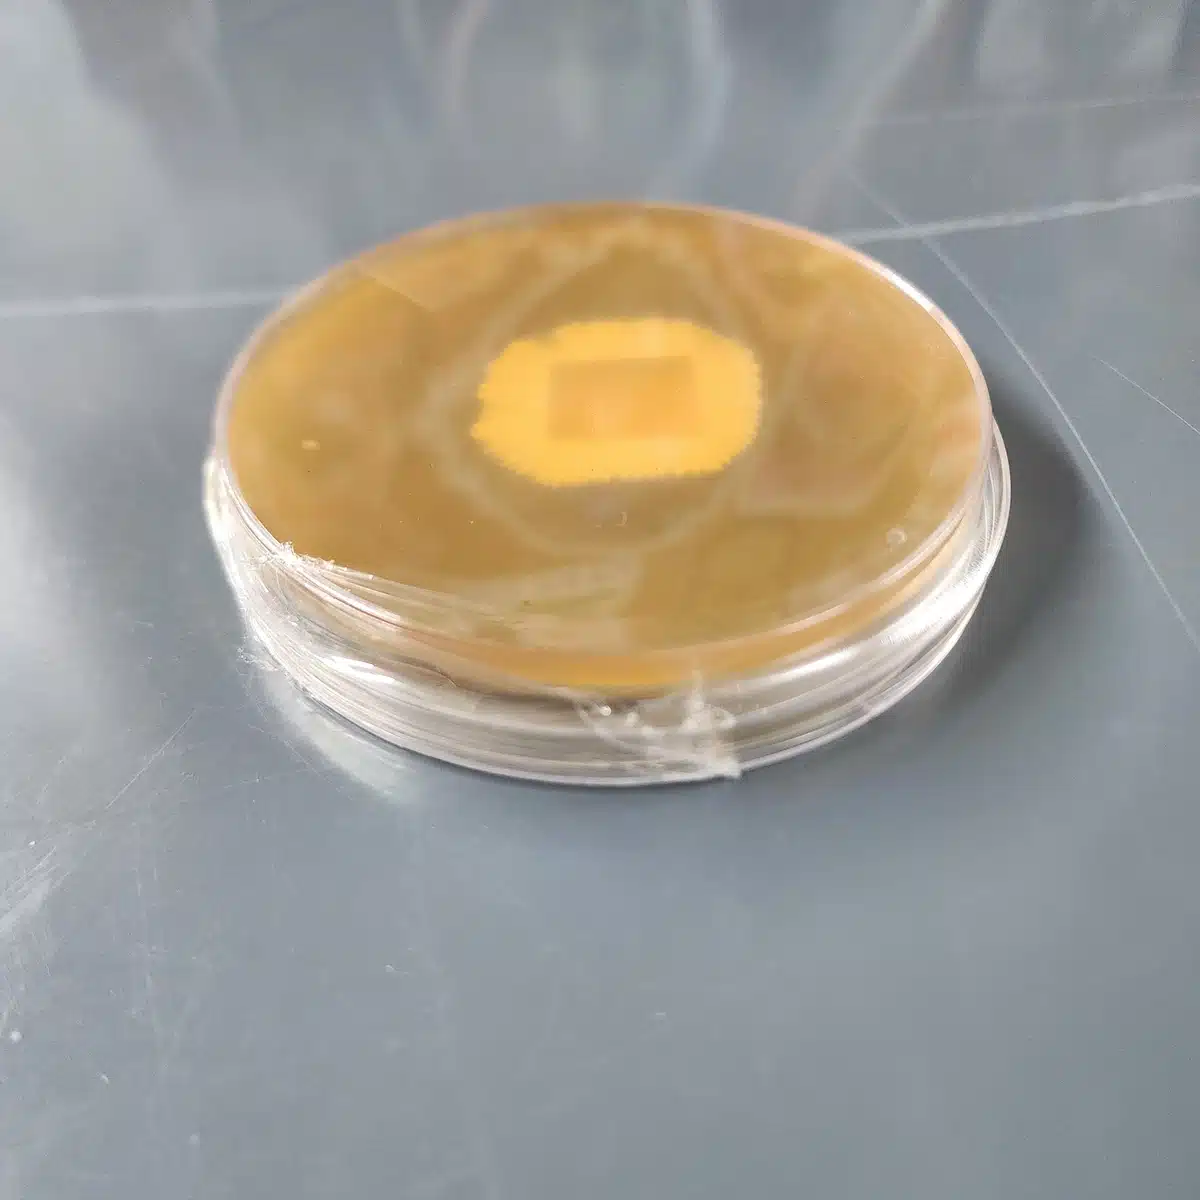

$8.99
Plate Wrap Film – 3 Roll Pack
Stretchable sealing film designed for wrapping Petri dishes, agar plates, and laboratory containers. This flexible wrap adheres to itself when stretched, creating a secure seal that helps protect cultures from dust and contamination while allowing slight gas exchange.
A practical and economical alternative to traditional laboratory wrap films, making it ideal for hobby mycology labs, classrooms, and research environments.
Includes:
• 3 rolls per order
• 1.6 inch width stretchable wrap film
In stock
- Satisfaction Guaranteed
- Secure Payments
Plate Wrap Film – Stretchable Lab Sealing Film (3 Rolls)
An economical and flexible plate wrap film designed for sealing Petri dishes, agar plates, and laboratory containers. This stretchable film creates a secure barrier around culture plates while still allowing slight gas exchange, making it ideal for many mycology and microbiology workflows.
Often used as a cost-effective alternative to Parafilm M and Seal‑R‑Film, this wrap film stretches easily and adheres to itself, allowing users to quickly seal plates and culture vessels during storage or observation.
Each order includes three rolls of film, providing plenty of material for wrapping large numbers of Petri dishes while keeping laboratory costs low.
Why Use Plate Wrap Film?
• Stretchable sealing film designed for Petri dishes and culture plates
• Creates a protective barrier against dust and contaminants
• Self-adhering when stretched and wrapped
• Allows slight gas exchange while maintaining plate integrity
• Cost-effective alternative to traditional laboratory wrap films
• Flexible and easy to apply without clips or tape
Ideal Uses in the Lab
This wrap film is commonly used for:
• Wrapping agar plates and Petri dishes
• Sealing culture slants or small containers
• Securing lids on sample jars or laboratory vessels
• Protecting plates during storage or transportation
• General laboratory sealing tasks
Many hobby mycologists and small labs use plate wrap films like this to maintain clean plate environments while cultures are being observed or archived.
Easy Application
Using the wrap film is simple:
-
Pull a short section from the roll
-
Stretch gently while wrapping around the edge of the Petri dish
-
Allow the film to overlap slightly for a tight seal
Because the film stretches significantly, a small amount goes a long way when sealing plates.
Product Specifications
Product: Plate Wrap Film
Roll Width: 1.6 inches
Material: Stretchable laboratory wrap film
Color: Clear
Quantity: 3 rolls per order
Use: Petri dish sealing and general laboratory wrapping